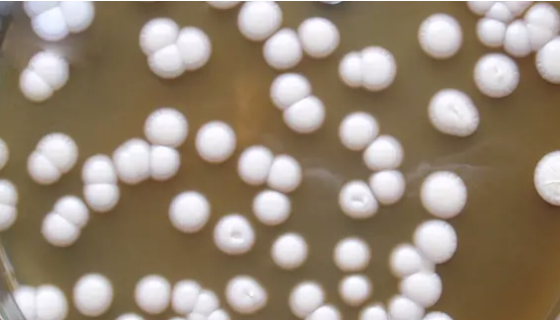
柱形假丝酵母的特点与优势及培养方法！
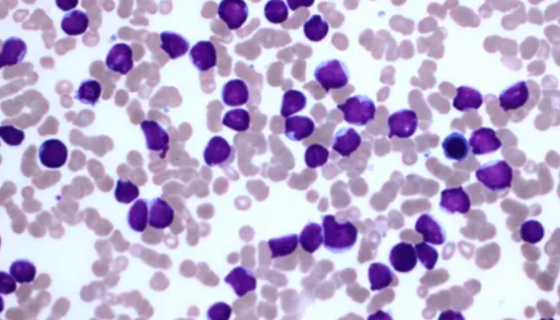
依赖性淋巴母细胞小鼠白血病细胞的培养步骤！
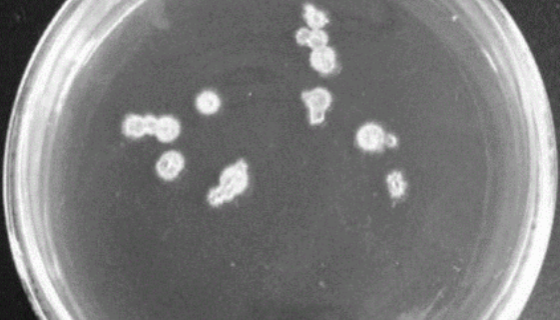
斯氏梭菌的菌株培养与实验内容及保存方法！

柱形假丝酵母的特点与优势及培养方法!
柱状假丝酵母(Candida cylindracea)又称为...

都柏林沙门氏菌的使用范围及培养与保藏方法!
都柏林沙门氏菌,为非模式菌株,培养温度:37℃,本菌可导致人...

ATCC 19402 诺氏梭菌的知识解析及注意事项!
诺氏梭菌Clostridium notyf }'i水神梭菌(...

德尔布有孢圆酵母——用于白酒酿造和产淀粉酶
德尔布有孢圆酵母是Torulaspora属的微生物,原产地为...
依赖性淋巴母细胞小鼠白血病细胞的培养步骤!
依赖性淋巴母细胞小鼠白血病细胞仅用于科学研究或者工业应用等非...

巴氏醋杆菌攀升亚种冻干管打管说明书!
巴氏醋杆菌巴氏亚种是Acetobacter属的微生物,原产地...

人阴道上皮细胞收到后的处理方法与培养步骤!
人阴道上皮细胞仅用于科学研究或者工业应用等非医疗目的不可用于...
斯氏梭菌的菌株培养与实验内容及保存方法!
斯氏梭菌,广泛使用到食品、药品、化妆品、水产品、化工等行业,...

MIO-M1视网膜Muller干细胞的消化与传代及处理方法!
MIO-M1,仅用于科学研究或者工业应用等非医疗目的不可用于...